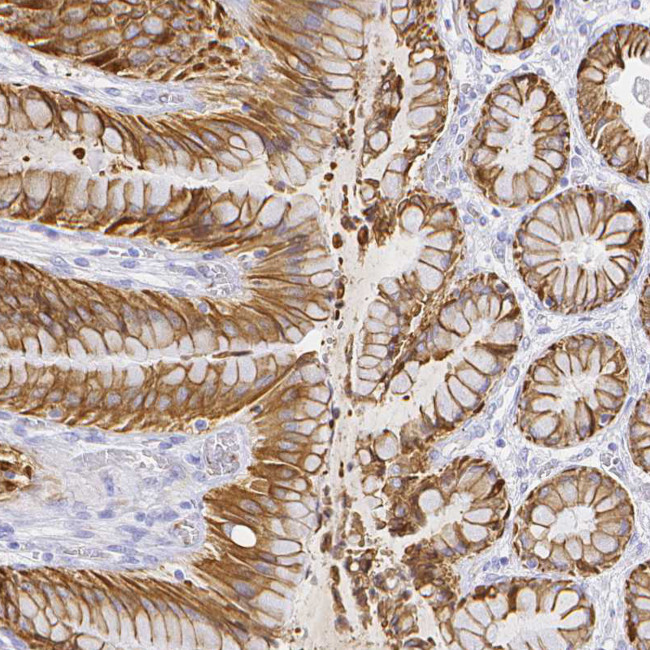
SMURF1 Antibody in Immunohistochemistry (Paraffin) (IHC (P))

Search
Invitrogen
SMURF1 Polyclonal Antibody
{{$productOrderCtrl.translations['antibody.pdp.commerceCard.promotion.promotions']}}
{{$productOrderCtrl.translations['antibody.pdp.commerceCard.promotion.viewpromo']}}
{{$productOrderCtrl.translations['antibody.pdp.commerceCard.promotion.promocode']}}: {{promo.promoCode}} {{promo.promoTitle}} {{promo.promoDescription}}. {{$productOrderCtrl.translations['antibody.pdp.commerceCard.promotion.learnmore']}}




Please note: We are reviewing Western blot images included in the antibody testing data in our catalog, including those provided by third parties. Unless expressly labeled or annotated as “raw-unedited”, Western blot images included in the antibody testing data in our catalog may have been edited, optimized or otherwise adjusted for presentation.
产品信息
PA5-111411
种属反应
宿主/亚型
分类
类型
抗原
偶联物
形式
浓度
规格
纯化类型
保存液
内含物
保存条件
运输条件
RRID
产品详细信息
Immunogen sequence: DSTGAAAGGG NCRFVESPSQ DQRLQAQRLR NPDVRGSLQT PQNRPHGHQS
Highest antigen sequence indentity to the following orthologs: Rat - 92%, Mouse - 90%.
靶标信息
Members of the transforming growth factor-beta (TGFB) family signal through type I and type II serine/threonine-kinase receptors, which in turn activate the SMAD signaling pathway. Bone morphogenetic protein (BMP) receptors target SMAD1, SMAD5, and SMAD8, whereas receptors for activin and TGFB (e. g., ACVR1 and TGFBR1, respectively) target SMAD2 and SMAD3. Phosphorylation of these receptor-regulated SMADs induces their association with the common-partner SMAD, SMAD4. Smurf1, a HECT domain E3 ubiquitin ligase, regulates cell polarity and protrusive activity and is required to maintain the transformed morphology and motility of a tumor cell. Atypical protein kinase C-zeta (PKC2), an effector of the Cdc42/Rac1-PAR6 polarity complex, recruits Smurf1 to cellular protrusions, where it controlled the local level of RhoA. Smurf1 thus links the polarity complex to degradation of RhoA in lamellipodia and filopodia to prevent RhoA signaling during dynamic membrane movements.
仅用于科研。不用于诊断过程。未经明确授权不得转售。
篇参考文献 (0)
生物信息学
蛋白别名: E3 ubiquitin-protein ligase SMURF1; HECT-type E3 ubiquitin transferase SMURF1; hSMURF1; hSMURF2; SMAD ubiquitination regulatory factor 1; SMAD-specific E3 ubiquitin-protein ligase 1
基因别名: KIAA1625; SMURF1
Entrez Gene ID: (Human) 57154